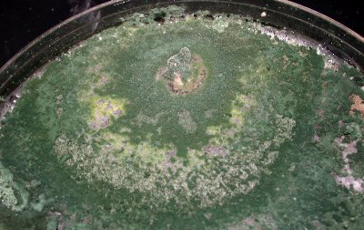

Dekomposer adalah organisme pengurai, atau organisme yang berperan dalam mendekomposisi biomassa di alam. Peran organisme pengurai pada suatu ekosistem sangatlah penting.
Dapat kita bayangkan apabila di alam ini tidak terdapat organisme yang berperan sebagai dekomposer, maka dunia ini akan dipenuhi dengan sampah-sampah organik dan biomass, baik sisa tanaman maupun bangkai hewan, yang jumlahnya menggunung.
Dekomposer berperan dalam siklus nutrisi di alam, terutama karbon. Proses dekomposisi ini penting untuk keberlangsungan siklus nutrisi di alam, mengembalikan nutrisi ke tanah dan menjaga keseimbangan ekosistem.
Organisme pengurai dapat dibedakan menjadi 2 yaitu makroorganisme, seperti protozoa, cacing, keong, siput, kumbang dan lain sebagainya, serta mikroorganisme yang terdiri dari fungi, bakteri dan aktinomiset. Salah satu kelompok fungi yang dikenal dan diketahui kemampuannya sebagai dekompser adalah Trichoderma.
Pengenalan tentang Trichoderma telah kami sajikan dalam artikel sebelumnya dengan judul Potensi Trichoderma Sebagai Bahan Aktif Pupuk Hayati dan Biostimulan.
Artikel kali ini akan membahas peran Trichoderma sebagai dekomposer, manfaatnya, dan bagaimana fungi ini dapat digunakan dalam praktik pertanian dan pengelolaan limbah organik.
Bagaimana Trichoderma Dapat Berperan Sebagai Dekomposer ?
Trichoderma dapat berperan sebagai dekomposer dikarenakan fungi ini mampu menghasilkan enzim-enzim yang bertugas untuk mendekomposisi komponen utama dinding sel penyusun tanaman, dimana dinding sel tersebut terdiri dari lignin, selulosa dan hemiselulosa.
Dari ketiga komponen ini, selulosa merupakan komponen utama yang menempati 50% – 70%, diikuti oleh lignin dan hemiselulosa.
Trichoderma diketahui mampu menghasilkan enzim selulase dan hemiselulase. Selulase adalah enzim yang mendekomposisi selulosa, sedangkan enzim hemiselulase adalah enzim yang mendekomposisi hemiselulosa.
Lebih lanjut kita bahas tentang enzim selulase…..
Untuk mendekomposisi selulosa secara menyeluruh, enzim selulase harus terdiri dari 3 komponen enzim, yaitu :
- Enzim selobiohidrolase
- Enzim endo-glukanase
- Enzim ekso-glukanase.
Ketiga komponen enzim ini bekerja secara sinergi untuk mendekomposisi atau mengurai rantai selulosa secara sempurna.
Trichoderma merupakan salah satu dari segelintir fungi yang memiliki ketiga komponen enzim tersebut.
Sebagian besar mikroba penghasil enzim selulase tidak memiliki komponen enzim yang lengkap sepertinyang dimiliki oleh Trichoderma.
Keunggulan ini menyebabkan kelompok fungi ini sering kali dijadikan komponen utama atau bahan aktif dalam suatu formula agensia dekomposer.
Apa Manfaat Dekomposer Trichoderma Untuk Pertanian, Perkebunan dan Hortikultura ?
1. Trichoderma memainkan peran kunci dalam proses dekomposisi sisa-sisa panenan/biomassa yang tertinggal di sawah maupun di ladang.
Petani jangan lagi membakar sisa-sisa jerami, melainkan cukup menebarkan dekomposer yang mengandung Trichoderma untuk mempercepat proses penguraian jerami tersebut.
2. Limbah perkebunan seperti tandan kosong kelapa sawit dapat didekomposisi menggunakan Trichoderma, sehingga cepat terurai menjadi bahan pupuk organik atau pembenah tanah. Demikian halnya dengan sisa-sisa panenan sayuran.
3. Trichoderma dapat ditebar di lahan-lahan pertanian pada saat pengolahan tanah, dengan tujuan untuk memperbanyak populasi mikroba dekomposer di lahan tersebut, sehingga penguraian bahan organik bisa berlangsung dengan efektif.
4. Dengan terdekomposisinya bahan organik atau biomassa maka nutrisi (N, P, K, Ca, Mg dan hara mikro) yang terdapat pada bahan tersebut akan dapat dimanfaatkan oleh tanaman sebagai sumber hara.
5. Karbon yang terkandung pada bahan organik yang telah terdekomposisi merupakan sumber makanan bagi mikroba di tanah.
6. Bahan organik atau biomassa yang terdekomposisi dapat berfungsi sebagai pembenah tanah, memperbaiki struktur tanah dan menjaga kelembaban tanah.
7. Dengan adanya bahan organik atau biomassa yang telah terurai di tanah maka pada akhirnya akan meningkatkan kesuburan dan kesehatan tanah yang berkelanjutan.
Dekomposer Trichoderma dapat digunakan untuk pengomposan kotoran ternak (sapi, ayam, kelinci, kambing), sisa-sisa limbah pasar, sampah-sampah baik sampah di tingkat rumah tangga maupun di TPA (Tempat Pembuangan Akhir). Proses pengomposan akan lebih cepat dan kompos yang dihasilkan akan lebih baik kualitasnya.
Menuju Berkelanjutan
Trichoderma sebagai dekomposer memainkan peran penting dalam mendukung pertanian berkelanjutan dan pengelolaan limbah organik.
Dengan kemampuannya menguraikan bahan organik menjadi nutrisi yang dapat diserap oleh tanaman, Trichoderma membantu memperbaiki kesuburan tanah, mengurangi limbah, dan meningkatkan hasil pertanian.
Penggunaan Trichoderma dalam pengomposan dan dekomposisi bahan organik adalah langkah maju menuju praktik pertanian yang berkelanjutan dan ramah lingkungan.
Inovasi produk dimulai dari mikroba yang tepat.
AHP menghadirkan inokulan mikroba berbasis riset untuk mendukung pengembangan agribisnis Anda.
Klik disini —> Inokulan mikroba untuk perusahaan Anda